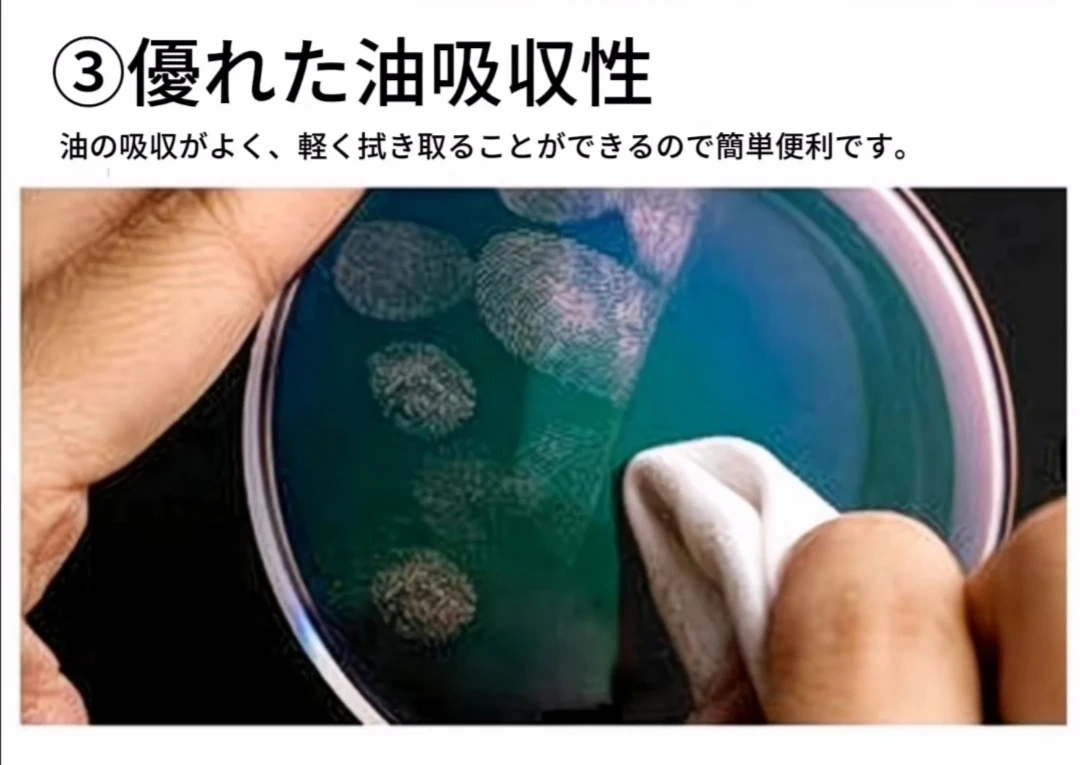

商品の特長・基本仕様 特長: ポリエステル超極細繊維を使用。表面積が大きいので、粘性の高い汚れを多量に拭き取る際に、優れた拭き取り性能を発揮します。 100%長繊維からなるニットタイプのワイピングクロスで、繊維の毛羽立ちや自己発塵が少ないワイパーです。端面レザーカット処理、ワイパー専用のクリーンルーム下での超純水洗浄加工により優れたリントフリー性を発揮します。 長極細繊維使用による毛細管現象と繊維間の空隙が多い事により、水や油、溶剤などを素早く吸収し、多量に保持します。 緻密で無数のミクロループが汚れをしっかりからめとります。 洗濯可能です。 途切れていない長い繊維から出来ているため、拭いた時に細かなケバが残りません。 用途: ①粘性の高い汚れを多量に拭き取る際に ②クリーンルーム内の清掃に ③眼鏡、スマホ、カメラのレンズ、ノートPC画面拭きに。清掃時クロスからの再付着が無く清掃が容易 メガネ拭きに使ったら今までのクロスよりクリア感がUP。 使用方法: 洗剤を使わず、レンズ表面の”油脂”を取り去ってくれます。眼鏡の場合は、軽く水洗いをしたのちに何度かふき取りをすると、新品のようにきれいになります。 手入れ: 使用後は、石鹸水で軽くもみ洗いをして、乾燥させると、ふき取り能 力は完全に復活します。 材質:ポリエステル超極細繊維 色:ホワイト 容量:1枚 シートサイズ:200×200(mm) 価格:1点500円 2点800円 3点1000円
- 商品の状態新品・未使用
取引はアプリでのみ可能です。
ダウンロードしてご利用ください。
ダウンロードしてご利用ください。
楽楽さんの出品
すべて見るアップル専用(iPhone、iPad、Mac)エアタグ(本体1点、英語バージョン使用説明書、CR2032電池2点) ホワイト
800円
登戸
首掛け扇風機 携帯扇風機 ネッククーラー ハンズフリー USB充電式 急速冷却 ハンディファン 風量5段階調節 熱中症対策
1,000円
登戸
首掛け扇風機 携帯扇風機 ネッククーラー ハンズフリー USB充電式 急速冷却 ハンディファン 風量5段階調節 熱中症対策
1,000円
登戸
新品未使用 葛飾北斎 <富嶽三十六景 神奈川沖浪裏>レゴ®アートセット
14,000円
登戸
可愛いキーホルダー 2色選べる
500円
登戸
ラブブぬいぐるみ 少年少女七彩心 1点 3色選べる
600円
登戸
人気商品
すべて見る